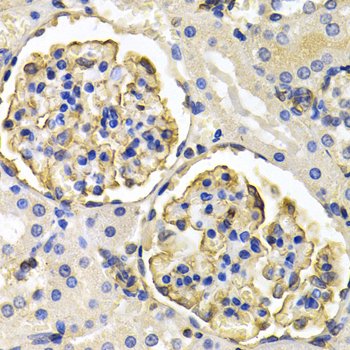
A5318: image 2

For quotations, please use our online quotation form, and you may also contact us by
sales@neoscientific.com
+1-888.733.6849
+1-617.299.7367 (Int’l)
+1-888.733.6849
+1-617.299.7367 (Int’l)
| Reactivity | Human Mouse Rat |
| Tested applications | WB IHC IF |
| Recommended Dilution | WB 1:500 - 1:2000 IHC 1:50 - 1:200 IF 1:50 - 1:200 |
| Calculated MW | 71kDa |
| Observed MW | Refer to Figures |
| Immunogen | Recombinant protein of human KLKB1 |
| Storage Buffer | Store at -20℃. Avoid freeze / thaw cycles. Buffer: PBS with 0.02% sodium azide, 50% glycerol, pH7.3. |
| Synonym | PPK; KLK3; |

Western blot analysis of extracts of various cell lines, using KLKB1 antibody.
Immunohistochemistry of paraffin-embedded rat kidney using KLKB1 antibody at dilution of 1:200 (400x lens).

Immunohistochemistry of paraffin-embedded rat brain using KLKB1 antibody at dilution of 1:200 (400x lens).

Immunohistochemistry of paraffin-embedded human colon cancer using KLKB1 antibody at dilution of 1:200 (400x lens).

Immunohistochemistry of paraffin-embedded human liver cancer using KLKB1 antibody at dilution of 1:200 (400x lens).

Immunofluorescence analysis of HeLa cell using KLKB1 antibody. Blue: DAPI for nuclear staining.
Plasma prekallikrein is a glycoprotein that participates in the surface-dependent activation of blood coagulation, fibrinolysis, kinin generation and inflammation. It is synthesized in the liver and secreted into the blood as a single polypeptide chain. Plasma prekallikrein is converted to plasma kallikrein by factor XIIa by the cleavage of an internal Arg-Ile bond. Plasma kallikrein therefore is composed of a heavy chain and a light chain held together by a disulphide bond. The heavy chain originates from the amino-terminal end of the zymogen and contains 4 tandem repeats of 90 or 91 amino acids. Each repeat harbors a novel structure called the apple domain. The heavy chain is required for the surface-dependent pro-coagulant activity of plasma kallikrein. The light chain contains the active site or catalytic domain of the enzyme and is homologous to the trypsin family of serine proteases. Plasma prekallikrein deficiency causes a prolonged activated partial thromboplastin time in patients.
N/A